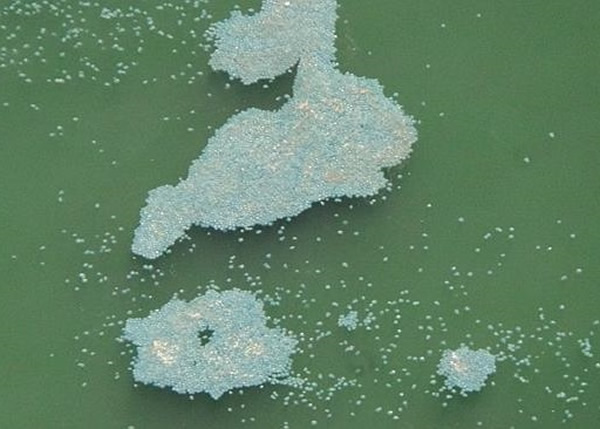
红崖海岸出现一大群水母(图)聚集

澳洲东南海岸发现奇怪水母群
红崖海岸出现一大群水母(图)聚集
专家指其品种属于马赛克水母
(神秘的地球报道)澳洲昆士兰东南沿岸城市红崖(Redcliffe),近日发现一大群水母聚集在该市附近的海域。专家暂家未亦清楚它们大量聚集的原因,以及会在该海域停留多久。
海洋生物学家汤姆森(Paul Thomson)周三表示,这些水母的品种是马赛克水母,于澳洲东部海岸非常普遍。而该种水母近年的数量持续反覆,于未来几年其数目将会变得极多,但又可于接下来的几年几乎消失不见。汤姆森解释今次现象时表示,通常水母群聚集是由于潮汐将它们推向海岸所致,但未知今次真正聚集的原因。
而当地的海岸救生服务队协调员麦克林托克(Tasman McClintock)表示,若人类被这种水母蛰到,会出现过敏或发炎,呼吁市民切勿主动接触它们。